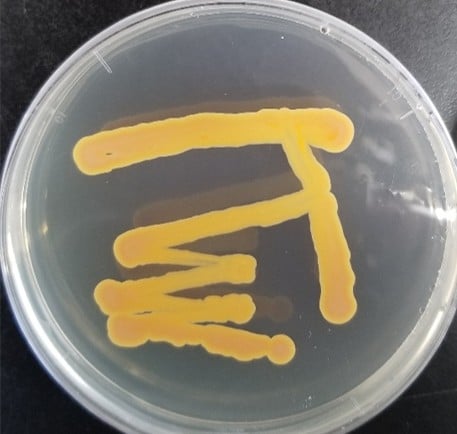

<コラム>身近な不思議が科学になるまで ― 高校生とともに進めた細菌研究
長浜バイオ大学 教授 地域連携・産官学連携推進室長 長谷川 慎
理系研究者と聞いて、皆さんはどのような姿を思い浮かべるでしょうか。白衣に身を包み、難解な実験や計算に没頭する姿を想像する人も多いかもしれません。しかし実際の研究は、日々の「なぜだろう」「本当かな?」という素朴な疑問から始まり、それを確かめるための工夫と試行錯誤の積み重ねによって形づくられていきます。
私たちは、大阪明星学園生物部の高校生の皆さんとともに、「環境中の細菌が作る化学物質」をテーマに共同研究を行いました。研究の出発点は、生徒さんの「魚の体の中に、病気から身を守るヒントが隠されているのではないか」という素朴な発想でした。そこで、スーパーマーケットで売っているキダイ(魚)の腸内細菌を試行錯誤で培養し、これら複数の細菌を同じ培地上で競合させる独自の「バクテリアバトル」といった実験法を編み出しました。バクテリアバトルというのは、固形培地の上で2種類の菌を重ねて培養し、どちらが優勢に増殖するか勝負させるというものです(この実験をやる前に、こちらの大学で無害な菌であることを確認しています)。トーナメント形式で、複数種類の菌(それぞれに色が少し異なります)をバトルさせて勝ち残った菌をみると、驚いたことにその菌の増殖した回りには他の菌が生えてきませんでした。歴史的なフレミングという科学者による抗生物質ペニシリンの発見に似た結果が得られたわけです。
この菌を大学で譲り受けて大学院生が調べた結果、この菌は放線菌門に属し、発酵させたナチュラルチーズの表面によく見つかる菌であることがわかりました。放線菌は、しばしば抗生物質などを作り出すことが知られています。それだけでなく、培養上清抽出物をディスク拡散法という方法で調べると、ブドウ球菌(病気の原因菌に近い種ですが無毒の株を使っています)の抑制効果を示す阻止円が確認されました(図参照)。その後、さらに研究を進め、抗菌作用を示す化学物質の構造を特定し、どうやら細菌同士のコミュニケーションに関連する物質らしいことがわかってきました。細菌は一匹ではなく、仲間が増えて一定の数に達すると、化学物質を合図としてコミュニケーションし、一斉に毒素や抗菌物質を作ったり、バイオフィルムと呼ばれる膜を形成したりします。今回見つかった化学物質は、どうやら他の菌には増殖を邪魔するのに、この菌自身の増殖速度は高めるらしいこともわかりました。

ここで強調したいのは、この研究の出発点が、高校生の皆さんの「不思議だな」「こうしたらどうなるだろう」という発想から生まれたということです。教科書に載っている知識は、すでに誰かが見つけた「答え」ですが、研究はまだ答えのない問いに挑む活動です。失敗することも多く、思い通りにいかないことの方が多いですが、その一つ一つが次の発見につながります。研究者になるということは、特別な才能を持つことではありません。身の回りの現象に興味を持ち、自分なりに考え、確かめてみる姿勢を大切にすることです。今回の共同研究が、皆さんにとって「研究は遠い世界の話ではなく、自分の好奇心から始められるものだ」と感じるきっかけになれば幸いです。そして、いつか皆さん自身の「なぜ?」が、新しい科学の一歩になることを期待しています。
